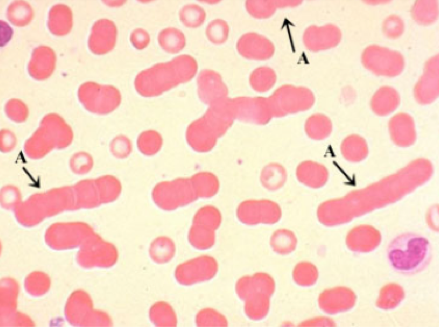

Sign up for FlowVella
Sign up with FacebookAlready have an account? Sign in now
By registering you are agreeing to our
Terms of Service
Loading Flow

Rouleax
These cells have a large fibrogen, globulins, and paraprotein. Their appearance is commonly described as "con-stacks"
Common diseases/conditions are acute and chronic inflammatory disorders, waldenstorms, and multiple myeloma.